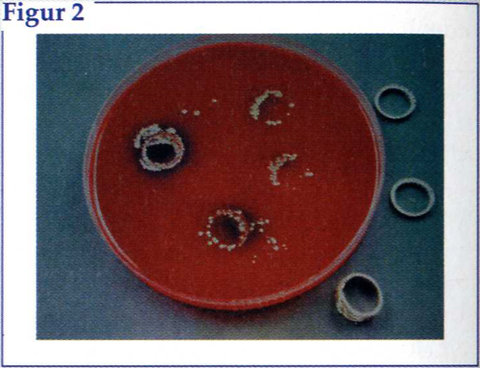

Sygeplejersken
Evidensbaserede standarder for håndhygiejne
Sundhedspersonale udfører kun håndhygiejne i langt under halvdelen af de situationer, de bør. Men undersøgelser viser, at de bliver bedre til at vaske hænder, når deres viden om håndhygiejne er baseret på evidens. I artiklen præsenteres denne evidens og de nyeste standarder for håndhygiejne.
Sygeplejersken 2004 nr. 19, s. 40-51
Af:
Lene Junker, hygiejnesygeplejerske,
Margrethe Meyer, hygiejnesygeplejerske,
Christine Wolff, arbejdsmiljøsygeplejerske

Artiklen henvender sig til sygeplejersker i primær og sekundær sundhedssektor, som arbejder med kliniske og undervisende opgaver.
Artiklens mål:
- At medvirke til bedre komplians af infektionshygiejnisk standard for håndhygiejne
- At forebygge arbejdsbetingede hudproblemer At læseren kan gøre rede for de væsentligste problemer inden for håndhygiejne
- At læseren kan gøre rede for hvorfor, hvordan og hvornår man skal vaske og pleje hænderne.
Børn i toårs alderen lærer at vaske hænder og gør det som rutine resten af livet. Men at udføre korrekt håndhygiejne i sundhedssektoren er noget helt andet. Konsekvenserne af manglende eller forkert udført håndhygiejne er store. Ellers vellykkede behandlingsresultater kan ødelægges, hvis der opstår infektion på grund af smitteoverførsel. Personale kan blive erkendt uarbejdsdygtige i lange perioder - måske for resten af arbejdslivet - hvis de pådrager sig alvorlige hudlidelser. Det er de barske konsekvenser.
Derfor er det vigtigt, at der er fokus på håndhygiejne, og som hygiejnesygeplejerske og arbejdsmiljøsygeplejerske kan man da også være sikker på, at emnet dukker op med jævne mellemrum.
Det kan dreje sig om personale, der henvender sig med hudproblemer, som de tilskriver handskerne, sæben eller den håndsprit, der findes i afdelingen. Eller det kan være hygiejnesygeplejersken, der i en afdeling observerer, at anbefalinger for, hvornår og hvordan man vasker hænder, ikke overholdes. Endelig kan det være mindre udbrud af infektioner i en afdeling, hvor en af årsagerne til smittespredningen som regel er manglende håndvask med vand og sæbe eller hygiejnisk hånddesinfektion med et spritholdigt desinfektionsmiddel.
Personalet i afdelingerne mener imidlertid, at de ofte hører om håndhygiejne, og at de gør, som vi beder dem om i retningslinierne.
Men hvorfor er det så svært at få en af de vigtigste infektionsforebyggende procedurer til at fungere i praksis?
Emnet diskuteres ofte mellem hygiejnesygeplejersker, men burde i virkeligheden diskuteres med det kliniske personale og deres ledere. Sygeplejersker og sundhedspersonale er i dag veluddannede og i stand til at indhente information og viden og på den baggrund træffe vigtige afgørelser om, hvordan de skal handle, så patienten får det bedst mulige resultat af hele indlæggelsesforløbet.
Spørgsmålet er, om vi giver personalet den viden om håndhygiejne, der sætter dem i stand til at handle korrekt.
Denne og den følgende artikel opsummerer tilgængelig viden på området og samler de danske anbefalinger inden for korrekt håndhygiejne og hudpleje.
Forebyggelse af infektioner
Undersøgelser har vist, at sundhedspersonalet inden for de sidste 20 år ikke er blevet bedre til at overholde de anbefalinger, der er for korrekt håndhygiejne (1,2,3).
Under 50 pct. udfører håndhygiejne, når det er påkrævet, og det er alt for få (se figur 1).
En af undersøgelserne i figur 1 er lavet i 1992 af hygiejnesygeplejerske Jette Zimakoff fra SSI. Det er en observations- og spørgeskemaundersøgelse der bl. a. afdækkede personalets viden om og holdninger til håndhygiejne (1).
Sidst har sundhedsplejersker gennem et håndhygiejneprojekt vist, at de ved en målrettet indsats har kunnet forbedre børnehavebørns håndhygiejne og nedsætte sygeligheden blandt børnene med 32 pct.
Metoden bestod i al sin enkelthed i, at børnene i én gruppe lærte at vaske hænder før måltider og efter toiletbesøg. I en anden gruppe undlod man påvirkning og undervisning (4).
Side 41

Tilsvarende kampagner for god håndhygiejne er søgt gennemført i det danske sundhedsvæsen, men tilsvarende positive resultater er ikke publiceret. Dette kan have flere årsager. En af dem er, at en del af sygehusinfektionerne skyldes infektioner med patientens egne bakterier og ikke udefra kommende bakterier.
En anden årsag kan være, at det ofte er flere forskellige brister i overholdelsen af de hygiejniske retningslinier, der fører til en infektion. Selv om manglende eller dårlig udført håndhygiejne er en vigtig risikofaktor, indgår der mange andre risikofaktorer i et undersøgelses- eller behandlingsforløb. Derfor kan man ikke altid se resultater efter at have reduceret en risikofaktor.
Håndhygiejne er blandt sundhedsprofessionelle udnævnt til den vigtigste procedure til at forhindre krydsinfektioner og sygehusinfektioner (5,6,7). Det blev slået fast, da den østrigske fødselslæge Ignaz Philipp Semmelweiss i 1848 i Wien påviste, at hygiejnisk hånddesinfektion med karbolvand kunne nedsætte dødeligheden hos barselkvinder fra ca. 17 pct. til ca. 2 pct. (8).
Smitten blev overført af bl.a. læger, som gik direkte fra obduktionsstuerne til fødegangen uden at vaske eller desinficere deres hænder først.
Det er ikke nemt at demonstrere, at infektioner stammer fra hændernes hudflora eller overføres via hænderne (9,10,11). At patogene mikroorganismer kan isoleres fra
Side 42
sundhedspersonalets hænder beviser ikke, at den pågældende bakteriestamme har været årsag til infektionen. At der er en sammenhæng mellem håndhygiejne og infektioner, konkluderede Larson dog tilbage i 1988 (12,13).
Hudens flora
Hvis man skal forstå anbefalingerne for god håndhygiejne, er det nødvendigt, at personalet har deres faglige baggrundsviden i orden.
Først lidt om hudens flora. Floraen kan deles op i to grupper:
Den dybereliggende hudflora, (som kaldes den permanente) omfatter mikroorganismer som:
- propionebakterier
- koagulase negative stafylokokker
- corynebakterier.
Disse bakterier er lokaliseret i de dybere liggende hudlag, hvor de lever og formerer sig i hudens sprækker og fordybninger. De er beskyttet af fedt og forhornet epitel og er for en dels vedkommende anaerobe. De er vanskelige at identificere med almindelige dyrkningsmetoder.
Den midlertidige, påførte hudflora - den transiente - omfatter samme bakterier, der ofte ses som årsag til hospitalsinfektioner, nemlig stafylokokker, streptokokker og gram negative bakterier.
De er lejret i hudens øverste lag eller i hornlaget og er individuelt sammensat, afhængig af faktorer som hudens tilstand, omgivende miljø, og hvor ofte hænderne bliver vasket.
Den transiente flora fjernes for det meste let ved almindelig håndvask eller ved hygiejnisk hånddesinfektion.
Bakterierne stammer ofte fra personalets kontakt med inficerede og koloniserede patienter eller fra forurenede hjælpemidler og omgivelser som f.eks. fade, kørestole, gangbarrer, håndtag, telefoner mm. De fleste af de påførte bakterier vil gå til grunde efter kort tid.
Flere undersøgelser har dog vist, at op til 30 pct. af personalet i intensive afdelinger og op til 80 pct. i neonatal- og brandsårsafdelinger er bærere af gram negative bakterier. Ved infektionsudbrud med gram negative bakterier har de samme typer kunnet isoleres fra plejepersonalets hænder (9,13,14). De påvirkes stort set ikke ved almindelig vask med vand og sæbe og kun i begrænset omfang af hygiejnisk hånddesinfektion (15). Bakterier fra omgivelserne kan overleve og formere sig på huden, og finder de en niche, kan de kolonisere huden og bliver dermed en del af den permanente hudflora.
Smitteveje
Hvordan overføres mikroorganismer via personalets hænder til andre patienter eller til udstyr i forbindelse med pleje og behandling?
For at det kan lade sig gøre, skal personalet som det første have forurenet deres hænder. Det kan ske ved et uheld, hvis der ikke anvendes handsker, eller hvis man ikke er bevidst om, hvad der er rent og hvad der er urent, dvs. hvad der er forurenet med patogene mikroorganismer.
Dernæst skal mikroorganismerne på personalets hænder være i stand til at overleve mindst nogle minutter, hvilket de fleste kan.
Hvis der herefter ikke udføres korrekt håndhygiejne, eller hvis den udføres med midler, der ikke er effektive, vil mikroorganismerne kunne overføres næste gang, den pågældende har kontakt til andre patienter, eller de kan afsættes på udstyr. Manglende rengøring og desinfektion af udstyret vil derfor føre til nye smittekilder.
Komplians
Håndhygiejne er noget af det første, man introduceres til, når man starter en karriere i sundhedsvæsenet. Men hvorfor er det så svært, at overholde gældende retningslinier i praksis?
Begrebet komplians har stor betydning. I denne sammenhæng skal non-komplians opfattes som manglende samarbejde, dvs. at sundhedspersonalet ikke overholder de gældende retningslinier for, hvornår der skal vaskes eller desinficeres hænder, at de anvender forkerte og utilstrækkelige metoder eller ineffektive midler.
Komplians opstår på baggrund af viden, information og forståelse (22).
Undersøgelser af håndhygiejniske anbefalinger viser, at viden, information og forståelse skal ses som en række faktorer, der indbyrdes er forbundet med hinanden.
I en undersøgelse fra 1987 beskrives, hvilke
Sied 43
faktorer der henholdsvis er motiverende og demotiverende i forhold til, om personalet udviser komplians (2).
En demotiverende faktor er manglende kendskab til gældende retningslinier og manglende anerkendelse af, hvornår der skal foretages håndhygiejne. Travlhed betyder en nedprioritering af håndhygiejnen, mens god viden om smitteforebyggelse er en motiverende faktor.
En motiverende faktor er nem adgang til håndvaske og gode hudprodukter som håndsprit, sæbe, creme og håndklæder af god kvalitet. Personalet undlader at have en ordentlig håndhygiejne, hvis de får hudproblemer af at bruge afdelingens hudprodukter.
Endelig fremhæves betydningen af eksemplets magt. Rollemodeller er kulturskabende, også når det drejer sig om god håndhygiejne.
En bred formidling, som hele tiden følges op, er det, der har den største effekt i positiv retning på komplians.
Rollemodeller
Netop diskussionen om, hvordan vi opfatter vore kolleger som rollemodeller, blusser jævnligt op i Sygeplejersken. Når sygeplejersker bliver fotograferet i forskellige
De sidste år er der sat fokus på arbejdet med at forebygge sygehusinfektioner og forhindre smitte (26). Det Centrale Afsnit for Sygehushygiejne på Statens Serum Institut har sammen med Dansk Standard i 1998 taget initiativ til udarbejdelse af Dansk Standard for infektionshygiejne (27).
Forskellige hygiejneorganisationer fra hele landet har deltaget i udarbejdelsen sammen med specialister inden for de kliniske områder, der er behandlet i standarderne, f.eks. ortopædkirurgi, gastoenterologi, og urologi. Udarbejdelsen af standarderne skal ses som en del af den stigende opmærksomhed, der er rettet mod kvalitetsstyring både i Danmark og i udlandet. Infektionshygiejnestandarderne har givet Danmark en særstilling internationalt og vil indgå i arbejdet med at udarbejde en national kvalitetsmodel. I de øvrige europæiske lande er der interesse for at undersøge, om den danske standard kan danne model for en europæisk standard på området.
De første standarder blev udsendt i 2001 og omfatter:
DS 2450 - Styring af infektionshygiejne i sundhedssektoren: Krav til ledelsessystemet. Denne er understøttet af DS 2451-serien, som består af tolv faglige delstandarder, der alle tager udgangspunkt i risikostyring.
Den standard, der omhandler håndhygiejne, er DS 2451-2: Krav til håndhygiejne (33). Den omfatter:
- almindelig håndvask
- hygiejnisk hånddesinfektion
- kirurgisk håndvask med desinfektion
- kirurgisk hygiejnisk hånddesinfektion
- medicinske engangshandsker.
I denne artikel er gennemgået:
- krav til almindelig håndvask
- hygiejnisk hånddesinfektion.
Desuden omtales medicinske engangshandsker kort.
Krav til kirurgisk håndvask med desinfektion, og kirurgisk hygiejnisk hånddesinfektion er ikke medtaget i denne artikel. Der henvises i stedet til standarden. Standarderne kan fås ved henvendelse til Dansk Standard tlf. 3996 6101 eller de kan kontaktes på netadressen www.ds.dk
Side 44
kliniske situationer iført smykker, lader reaktionen sjældent vente på sig. For os, der har til opgave at undervise i og implementere gode infektionshygiejniske retningslinier og vaner, er det klart, at disse billeder sender et forkert signal.
Sygeplejersken ønsker ikke at censurere billederne. Men hvordan får vi i stedet det personale, som lader sig fotografere til bladet, til at forstå, at infektionshygiejne indgår i alle kliniske situationer? Derfor bør hygiejnen også indgå i Sygeplejerskens illustrationer som en naturlig del. Ingen vil vel stille sig op og demonstrere injektionsgivning med en knækket kanyle?
Så kære sygeplejersker, som stiller op til fotografering: Det er op til jer at være gode rollemodeller.
Et eksempel på, hvordan personalet kan inddrages aktivt og med ledelsens fulde engagement og støtte, er vist i ”Sund hud på arbejdet,” som omtales nærmere i artiklen ”Forebyggelse af hudlidelser på hænderne” side 48.
Et eksempel på, hvordan personalet kan inddrages aktivt og med ledelsens fulde engagement og støtte, er vist i ”Sund hud på arbejdet,” som omtales nærmere i artiklen ”Forebyggelse af hudlidelser på hænderne” side 48.
Mange bakterier kan gemmes under en fingerring
Håndhygiejne i praksis
Med nutidens komplicerede pleje og behandlingsforløb er det ikke tilstrækkeligt at udføre håndhygiejne før og efter kontakt med patienterne.
Håndhygiejne må ofte udføres mellem forskellige procedurer hos samme patient, f.eks. skift af forbinding, tømning af timediuresemåler og hjælp til personligt toilette.
Formålet med håndhygiejne er:
- at fjerne den påførte (transiente) bakterieflora og reducere den permanente bakterieflora på hænderne før kontakt med patienter og udstyr
- at forebygge, at mikroorganismerne fra plejepersonalets hænder overføres til andre med risiko for infektion.
Her følger eksempler på, hvornår håndhygiejne skal udføres:
- før alle rene og sterile procedurer
- før måltider eller håndtering af madvarer
- efter direkte patientkontakt
- efter urent arbejde, f.eks. ved berøring med blod, vævsvæske, urin eller afføring
- efter toiletbesøg
- efter hoste, nys og næsepudsning
- efter brug af handsker (pga. risiko for mikroskopiske huller og opformering af bakterier i handsken). Samtidig fjernes hudskadelige kemikalier.
De områder, man skal være specielt opmærksom på, og som man kan gøre noget for at påvirke, benævnes risikoområder eller risikofaktorer. I håndhygiejnestandarden er risikofaktorerne defineret som:
- hænder, håndled og underarme
- håndhygiejnefaciliteter
- håndhygiejnemidler
- håndhygiejneteknik.
For at kunne udføre en ordentlig og effektiv håndhygiejne er det vigtigt, at der ikke bæres ringe, ure, armbånd eller kunstige negle. Mange bakterier kan gemmes under en fingerring (se figur 2), og det må opfattes som uprofessionelt, at der fortsat er personale, der bærer håndsmykker i forbindelse med pleje og behandling af patienter (28). En anden forudsætning er god hudpleje og rene, kortklippede negle, da bakterierne vil have gode muligheder for at etablere sig i en ru og sprukken hud, ved ødelagte neglebånd og under lange eller kunstige negle (29). Alle områder på hænderne skal vaskes omhyggeligt.
Det forudsætter også, at de fysiske rammer, dvs. håndvask og vandhaner, er i orden (se figur 3).
Hudvenlig håndvask
Håndvask udføres med fast håndsæbe ophængt i magnet eller ved hjælp af flydende sæbe i engangsdispenser, der skal være albuebetjent.
Hvis man anvender fast sæbe, der er ophængt i magnet, er det vigtigt at sæben afskylles
Side 45
Klik på figuren for større visning

og hænges op på magneten hver gang. På fast sæbe der ligger på håndvasken eller i en sæbeskål, kan bakterierne formere sig i den våde opløste sæbe. Flydende sæbe skal være bakteriologisk kontrolleret.
Alle sæber skal være hudvenlige og må ikke være tilsat farvestoffer eller parfume. Hænder og håndled fugtes i lunkent vand, inden sæben påføres.
Når der anvendes flydende sæbe, er det vigtigt, at hænderne er gjort grundigt våde, inden sæben påføres. I modsat fald vil de vaskeaktive stoffer let kunne give hudproblemer, når de kommer på den tørre hud.
Side 46
Sæben fordeles på alle fingre, mellem fingrene, inde i håndfladen, på håndryggen og omkring håndled. Vær især omhyggelig omkring negle og neglefalse.
Vask, så sæben mekanisk bearbejdes ind i mindst 15 sekunder.
Hænderne skylles grundigt under rindende vand, så sæberester undgås
Hænderne duppes/tørres i et rent engangshåndklæde. (Anvendes flergangshåndklæder, skal de lægges til vask efter at være brugt én gang).
Håndbetjente vandhaner lukkes med det brugte håndklæde.
Der skal efter behov anvendes en fed håndcreme uden parfume og tilsætningsstoffer. Undgå fælles cremetuber, der står på håndvasken, hvor de let bliver forurenede og kan være årsag til smittespredning. Anvend i stedet cremer med en pumpe/dispenser eller en personlig tube.
Figur 4 viser, hvilke områder på hænderne det ofte er svært at få vasket tilstrækkeligt effektivt.
Hygiejnisk hånddesinfektion
Ved hygiejnisk hånddesinfektion forstås indgnidning af hænderne med et desinfektionsmiddel, der indeholder mindst 70-85 pct. alkohol.
Hygiejnisk hånddesinfektion udføres:
- før rene procedurer
- efter ikke rene procedurer
- efter brug af medicinske engangshandsker hvis de er pudderfri. Hvis der er anvendt pudrede handsker, skal hænderne vaskes for at fjerne pudderet.
Brug af håndsprit indebærer mange fordele. Først og fremmest fjernes flere mikroorganismer ved brug af håndsprit i korrekt styrke end ved en almindelig håndvask (30,31).
Da håndsprit indeholder hudplejemiddel vil mange opleve, at det føles mildere mod huden end vask med vand og sæbe i forbindelse med hyppig håndhygiejne (32).
Huddesinfektion på synligt ren og tør hud.
- spritten fordeles og indgnides overalt på samme måde som sæben, men uden brug af vand. Der anvendes mindst 2 ml håndsprit.
- håndspritten indgnides til tørhed. Den mekaniske effekt ved indgnidningen er vigtig. Sprit kan ikke anvendes, hvis hænderne er synligt forurenede, våde eller ved et uheld er blevet forurenet med blod, sekret eller ekskret. I de situationer er det nødvendigt at vaske hænderne først.
Hvem er rollemodeller i din afdeling?
Prøv at diskutere det og finde ud af om de er gode eller dårlige rollemodeller.
Kender du de midler til håndhygiejne, der tilbydes i dit sygehus? Prøv at se om indholdsstofferne lever op til anbefalingerne i artiklen.
Prøv - evt. sammen med en kollega - at udføre en korrekt håndvask efter anvisningerne. Observer, hvor lang tid det tager.
Hvor ofte anvender du håndsprit i stedet for håndvask? Tag en snak med dine kolleger om, hvornår I gør hvad.
Desuden kan håndsprit anvendes, hvor der ikke er etableret en håndvask. Det er hurtigere at anvende, og man kan bevæge sig videre, mens hygiejnisk hånddesinfektion udføres. I mange situationer er en dispenser (plastflaske i lommestørrelse) en god løsning for personalet. Det gælder f.eks. i områder som anæstesi, intensiv, opvågning, psykiatri og i primær sektor.
I Sygeplejersken nr. 26/2002 var der refereret en undersøgelse, der tidligere havde været publiceret i det ansete engelske lægetidsskrift The Lancet. Artiklen fortæller om forsøg med forskellige typer rensegel til håndhygiejne. Flere af de testede produkter kom i undersøgelsen ud med dårlige resultater. Derfor gav artiklen anledning til undren og bekymring hos en del sundhedspersonale, der blev usikre på, om de midler, de anvendte, var gode nok.
De midler, der var testet i artiklen, indeholdt imidlertid ikke mere end omkring 60 pct. alkohol og tilhørte dermed ikke den type håndsprit, der anbefales i Danmark. I håndhygiejnestandarden er anført et krav om, at alkoholprocenten skal være mellem 70 og 85 pct., således som det også er anført i Råd amp; Anvisninger om Desinfektion i sundhedssektoren fra Det Centrale Afsnit for Sygehushygiejne, Statens Serum Institut. (33). I håndhygiejnestandarden er desuden angivet, at hygiejniske hånddesinfektionsmidler skal være testede og opfylde kravene til et desinfektionsmiddel, som det er angivet i EN 1500 som er en europæisk standard for test af hygiejnisk hånddesinfektionsmidler.
Dette er nye krav for de firmaer, der fremstiller og sælger produkterne.
Side 47
Endelig er det vigtigt, at håndspritten skal være tilsat hudplejemiddel for at kompensere for sprittens udtørrende effekt. I Danmark anvendes hovedsageligt ethanolsprit til håndsprit. Tidligere anvendte mange klorhexidinsprit, men for at undgå udvikling af allergi anbefales det i dag kun til kirurgisk hygiejnisk hånddesinfektion og bør ikke anvendes til hygiejnisk hånddesinfektion.
En del sundhedspersonale angiver, at de ikke tåler håndsprit, eller at det er den hyppige håndvask og midlerne dertil, der er et problem. Det er vigtigt at være opmærksom på, at alle trin i proceduren følges for at undgå disse problemer.
Der bør anvendes en håndsprit, der er optaget i Råd og Anvisninger om Desinfektion i Sundhedssektoren fra Afdelingen for Antibiotikaresistens og Sygehushygiejne, SSI (www.ssi.dk).
Hvordan hygiejnisk hånddesinfektion udføres fremgår af boks side 46.
Implementering af hygiejniske standarder
Semmelweiss konkluderede i 1847, at håndhygiejne er den vigtigste procedure til at forhindre kryds- og sygehusinfektioner. Undersøgelser har vist, at sundhedspersonale kun udfører håndhygiejne i langt under halvdelen af de situationer, de bør.
For at rette op på disse kendsgerninger må vi se på håndhygiejne i et bredere perspektiv.
I undersøgelser af virkningen af håndhygiejniske anbefalinger, viser det sig, at der er en række faktorer, som påvirker hinanden. Vi skal i langt højere grad anvende denne viden, når vi planlægger aktiviteterne ved implementeringen af de hygiejniske standarder. Dansk Standard for Infektionshygiejne er et stort skridt i den rigtige retning. Nu findes der evidensbaserede retningslinier for, hvornår og hvordan håndhygiejne skal udføres. Evidens har vist sig at være af stor betydning for sundhedspersonalets forståelse, når retningslinierne skal implementeres.
Brugen af håndsprit tilsat hudplejemiddel skal have større udbredelse og anvendes som et mere effektivt middel i stedet for håndvask. Forsøg har vist, at det formentligt også er mere skånsomt for huden. Disse forsøg bør fortsætte, og vi opfordrer producenterne til fortsat at forbedre håndspritprodukterne.
Der skal være mere fokus på valg af håndhygiejneprodukter, og det er en god investering at gøre mere ud af, hvilke midler der skal anvendes. Valg og indkøb af hudplejemidler og handsker bør foregå i et samarbejde mellem indkøbsfunktionerne og det kliniske personale. Det er vigtigt at få indkøbt de rigtige produkter, og det bliver dermed et led i bestræbelserne på at øge personalets komplians.
Gode produkter i form af milde og behagelige håndvaskemidler, håndsprit og gerne flere forskellige typer af plejecremer, har vist sig at have stor betydning for, om ny retningslinier bliver overholdt. Håndklæder bør også være af et godt og hudvenligt materiale.
Viden er en motiverende faktor og ”Sund hud på arbejdet” har vist, at det betaler sig at investere i formidlingen af eksisterende viden. Undervisning med udgangspunkt i afdelingens praksis, brug af ressourcepersoner og ledelsens opbakning og aktive støtte har givet gode resultater i form af ændret adfærd. Dermed er forebyggelse af hudproblemer blevet forbederet. Forebyggelseskonceptet vil kunne anvendes i forbindelse med implementering af god håndhygiejne.
Betydningen af rollemodeller kan ikke understreges nok. Undersøgelser af, hvad der skal til for at ændre praksis i en positiv retning, viser alle entydigt, at gode rollemodeller har afgørende betydning (2,3).
Håndhygiejne udføres både for at beskytte personalet og patienterne. I det enkelte menneskes oplevelse af risiko indgår tillid, viden, erfaringer og værdinormer (24,25). En undersøgelse viste, at mange opfattede den hyppige håndvask og midlerne som en risiko for at få ødelagt deres hud (1,2).
Hvis man kan sikre, at personalet har viden, tillid til informationerne og til valg af produkter, fremgår det, at personalet vil prioritere beskyttelse af patienten højere og ikke være bange for selv at pådrage sig hudgener.
Vi har tilstrækkelig viden, og vi har midlerne til at handle. Så det behøver ikke være så svært.
 Lene Junker, hygiejnesygeplejerske, Rigshospitalet
Lene Junker, hygiejnesygeplejerske, Rigshospitalet
Lene Junker er uddannet i 1970 fra Silkeborg Sygeplejeskole. Har arbejdet med hjertesygdomme på ÅrhuAs Aog på Rigshospitalet fra 1970 til 1976. Var med til at starte intensiv afdeling ITA 104 på Herlev Amtssygehus. Efter videreuddannelse ved Danmarks Sygeplejerskehøjskole i 1977-78 arbejdede hun som sygeplejelærer i Uddannelsesafdelingen på Kommunehospitalet i København i seks år. Uddannelsen til hygiejnesygeplejerske tog Lene Junker i 1990 på Den Centrale afdeling for Sygehushygiejne. Statens Serum Institut. Hun har siden 2001 været ansat som hygiejnesygeplejerske i Infektionshygiejnisk Enhed ved Rigshospitalet og har i syv år siddet i bestyrelsen for Dansk Selskab for Hygiejnesygeplejersker. Lene Junker har publiceret adskillige artikler i Sygeplejersken.
 Margrethe Meyer, hygiejnesygeplejerske, H:S Rigshospitalet
Margrethe Meyer, hygiejnesygeplejerske, H:S Rigshospitalet
Margrethe Meyer er uddannet fra Bispebjerg Sygeplejeskole i 1965. Hun tog diplomuddannelsen fra Danmarks Sygeplejerskehøjskole i 1969 i ledelse og undervisning og Sygeplejefaglig afgangseksamen i 1988. I 1984 blev hun uddannet til hygiejnesygeplejerske. Margrethe Meyer har arbejdet som hygiejnesygeplejerske siden 1977. Først på Bispebjerg Hospital og senere i Den Centrale Afdeling for Sygehushygiejne på Statens Serum Institut. Kom i 1998 til Rigshospitalet som hygiejnesygeplejerske, hvilket var starten på den første selvstændige afdeling for infektionshygiejne i Danmark. Margrethe Meyer er formand for Uddannelsesudvalget for Specialuddannelsen for sygeplejersker i infektionshygiejne og forfatter og medforfatter til en lang række artikler og bøger.
 Christine Wolff, arbejdsmiljøsygeplejerske
Christine Wolff, arbejdsmiljøsygeplejerske
Christine Wolff er uddannet i 1968 fra Bispebjerg Sygeplejeskole. Hun tog i 1977 diplomuddannelsen i ledelse og undervisning fra Danmarks Sygeplejerskehøjskole. Hun har bred ledelses- og undervisningsmæssig erfaring og har siden 1987 været beskæftiget som arbejdsmiljøsygeplejerske i H:S Arbejds- og Miljømedicinsk Klinik, Bispebjerg Hospital. Hun er medforfatter til lærebogen ”Sundhed, Menneske, Arbejde.” Christine Wolff har medvirket til etablering af ”Uddannelse til arbejdsmiljøsygeplejerske.” Hun har gennemført og publiceret flere undersøgelser vedr. arbejdsbetingede hudlidelser med fokus på forebyggelse og sundhedsfremme. Christine Wolff har i perioden 1997-2000 været en af de tre aktører i ”Sund hud på arbejdspladsen.” Resultaterne er publiceret i flere internationale dermatologiske og arbejdsmedicinske tidsskrifter.
1. Forbedret håndhygiejne i børnehaver kan nedsætte børnenes sygelighed med?
a. 20 pct.
b. 32 pct.
c. 50 pct.
d. 10 pct.
2. Den permanente hudflora:
a. Fjernes let med sæbe
b. Fjernes kun ved både håndvask og hygiejnisk hånddesinfektion
c. Fjernes kun i begrænset omfang ved brug af håndsprit
d. Fjernes ved brug af håndsprit
3. Huden på hænderne skal være velplejet fordi:
a. Det ser hygiejnisk ud
b. Huden tåler bedre håndsprit flere gange om dagen
c. Der sidder færre bakterier på en hel og velplejet hud
4. Hvad er en risikofaktor for håndeksem?
a. Hyppig håndvask
b. Vådt arbejde
c. Snavset arbejde
5. Hvilket handskemateriale yder bedst beskyttelse mod biologisk materiale?
a. Nitril (kunstgummi)
b. Plastik
c. Latex (naturgummi)
d. Vinyl
6. Hvad er kontakteksem?
a. En betændelsestilstand som følge af kontakt til hudskadelige stoffer
b. En medfødt hudlidelse
c. En smitsom hudsygdom
7. Tør og irriteret hud på hænderne kan være tegn på:
a. Dehydrering
b. Vægttab
c. Eksem
8. Den Danske Hygiejnestandard beskriver krav til:
a. Håndvask#3b. Hygiejnisk hånddesinfektion
c. Almindelig håndvask og kirurgisk håndvask
d. Håndhygiejne (almindelig håndvask, hygiejnisk hånddesinfektion, kirurgisk håndvask med desinfektion, kirurgisk hygiejnisk hånddesinfektion, medicinske engangshandsker)
9. Hvornår fjernes der flest mikroorganismer fra hænderne?
a. Ved håndvask
b. Ved hygiejnisk hånddesinfektion med et middel indeholdende alkohol
10. Hænderne skal vaskes med sæbe i mindst:
a. 3 sekunder
b. 1 minut
c. 20 sekunder
d. 15 sekunder
11. Flydende sæbe skal påføres våd hud fordi:
a. Sæben skummer bedre på våd hud
b. Ellers er den svær at skylle rigtig af igen
c. De vaskeaktive stoffer kan give hudirritation
12. En effektiv håndsprit på ethanolbasis skal indeholde mindst:
a. 20-35 pct. alkohol
b. 50-60 pct, alkohol
c. 70-85 pct. alkohol
d. 80-90 pct. alkohol
1. svar nr. B
2. svar nr. C
3. svar nr. C
4. svar nr. B
5. svar nr. C
6. svar nr. A
7. svar nr. C
8. svar nr. D
9. svar nr. B
10. svar nr. D
11. svar nr. C
12. svar nr. C
Video: Hånddesinfektion som intervention
Litteratur
- Zimakoff J. Evaluering af sygehuspersonalets håndhygiejniske adfærd, viden og holdninger. PhD afhandling. København; 1993.
- Zimakoff J. Håndhygiejne. En holdningsundersøgelse. Ugeskrift f Læger 1987;42:2872-75.
- Pittet D. Improving Compliance With Hand Hygiene in Hospitals. Infection Control and Hospital Epidemiology 2000;21(6):381-6.
- Ladegaard MB., Stage V. Håndhygiejne og småbørnssygelighed i daginstitutioner. Ugeskrift f Læger 1999;161(31):4396-4400.
- Nyström B. Impact of Handwashing on Mortality in Intensive Care: Examination of the Evidence. Infection Control and Hospital Epidemiology 1994;15(7):435-6.
- Pittet D. Compliance with hand disinfection and its impact on hospital-acquired infections. The journal of Hospital Infection Supplement A. 2001;48:40-6.
- Steere AC, Mallison GF. Handwashing Practices for the Prevention of Nosocomial Infections. Annals of Internal Medicine 1975;83(5):683-90.
- Simmelweiss IP. Childbed fever.Rev. Infect. Diseases 1981; 3: 808-811.
- Gould D. Nurses´ hands as vectors of hospital-acquired infection: a review. Journal of Advanced Nursing 1991;16:1216-25.
- Perdreau-Remington F, Stefanik D, Peters G, Ruckdeschel G, Haas F, Wenzel R, Pulverer G. Methicillin-resistant Stapylococcus haemolyticus on the hands of health care workers: a route of transmission or a source? Journal of Hospital Infection 1995;31:195-203.
- Hugonnet S, Pittet D. Hand hygiene. Beliefs or science? CMI 2000;6:350-6.
- Larson E. A Causal Link Between Handwashing and Risk of Infection? Examination of the Evidence. Infection Control and Hospital Epidemiology 1988;9(1):28-36.
- Casewell M, Phillips I. Hands as a route of transmission for Kleibsiella species. British Medical Journal1997;2:1315-17.
- Pittet D., Sauvan V. Bacterial Contamination of the Hands of Hospital Staff During Routine Patient Care. Arch Intern Med 1999;159:821-6.
- Lowbury E, Lily HA, Bull JP. Desinfections of the hands. Removal of transient organisms. British Medical Journal 1964;2: 230-33.
- Ramsing DW. Hudpåvirkning og profylakse i våde erhverv. PhD afhandling. Københavns Universitet; 1997.
- Ramsing DW, Agner T. Effect of water on experimentally irritated human skin. Br j Dermatol 1997;136:364-367.
- Meding B, Swanbeck G. Epidemiology of different types of hand eczema in an industrial city. Acta Derm Venerol (Stockholm) 1989;69:227-233.
- Arbejdsskadestyrelsens Statistik 1999, ASK 1999.
- Halkier-Sørensen L, Thestrup Pedersen K, Pedersen BH. Anmeldte og anerkendte hudsygdomme i Danmark. København: Industriens Forlag; 1994.
- Held E, Mygind K, Wolff C, Gyntelberg F, Agner T. Prevention of work related skin problems. An intervention study in wet work employees. Occupationel and Enviromental Medicine 2002;59:561-66.
- Elsass P. Sundhedspsykologi. København: Nyt Nordisk Forlag;1995.
- Larson EL, Bryan JL, Adler LM, Blane C. A multifaceted approach to changing handwashing behavior. AJIC 1997;25(1):3-10.
- Grandjean P, et al. Oplevelse af risici. Rapport fra en arbejdsgruppe. Miljø og sundhed. Supplement nr. 1, may 2001.
- Grandjean P. Farlig forurening. Fra risikovurdering til forebyggelse. København: Nyt Nordisk Forlag Arnold Busck;1997.
- Boyce JM, Pittet D. Guideline for Hand Hygiene in Health-Care Settings. Infection Control and Hospital Epidemiology Supplement 2002;23(12).
- Styring af infektionshygiejne i sundhedssektoren. Del 2: Krav til håndhygiejne. DS 2451-2. Dansk Standard 1. udgave 2001.
- Hoffman PN, Cooke EM, McCarville MR, Emmerson AM. Microorganisms isolated from skin under wedding rings worn by hospital staff. British Medical Journal 1985;290:206-7.
- Baumgardner CA, Maragos CS, Walz J, Larson E. Effects of Nail Polish on Microbial Growth of Fingernails. AORN Journal 1993;58(1):84-88.
- Rotter ML. Hand Washing and Hand Disinfection. In: Mayhall CG, editor. Hospital Epidemiology and Infection Control, 2.edition. USA: Lippincott Williams amp; Wilkins;1999.p.1339-55.
- Widmer AF. Replace hand washing with use of a waterless alcohol hand rub? Clin Infect Dis 2000;31:136-43.
- Kramer A, Bernig T, Kampf G. Clinical double-blind trial on the dermal tolerance and user acceptability of six alcohol-based hand disinfectants for hygienic hand disinfection. The Journal of Hospital Infection 2002;51: 114-120.
- Råd og Anvisninger om Desinfektion I Sundhedssektoren. 1997. Den centrale afdeling for sygehushygiejne. SSI.
- Ramsing DW, Agner T. Preventive and therapeutic effect of a moisturizer. An experiment study on human skin. Acta Derm Venerol 1997;77:335-7.
- Ramsing DW, Agner T. Effect of glove occlusion on human skin(1) Short term experimental exposure. Contact Derm 1996;34:1-5.
- Ramsing DW, Agner T. Effect of glove occlusion in human skin(2) Long term experimental exposure. Contact Derm 1996;34:258-62.
- Held E, Mygind K, Wolff C. Sund hud på arbejde. Et interventionsstudie. Forskningsrapport. Arbejdsmiljørådets Servicecenter; 2002.
